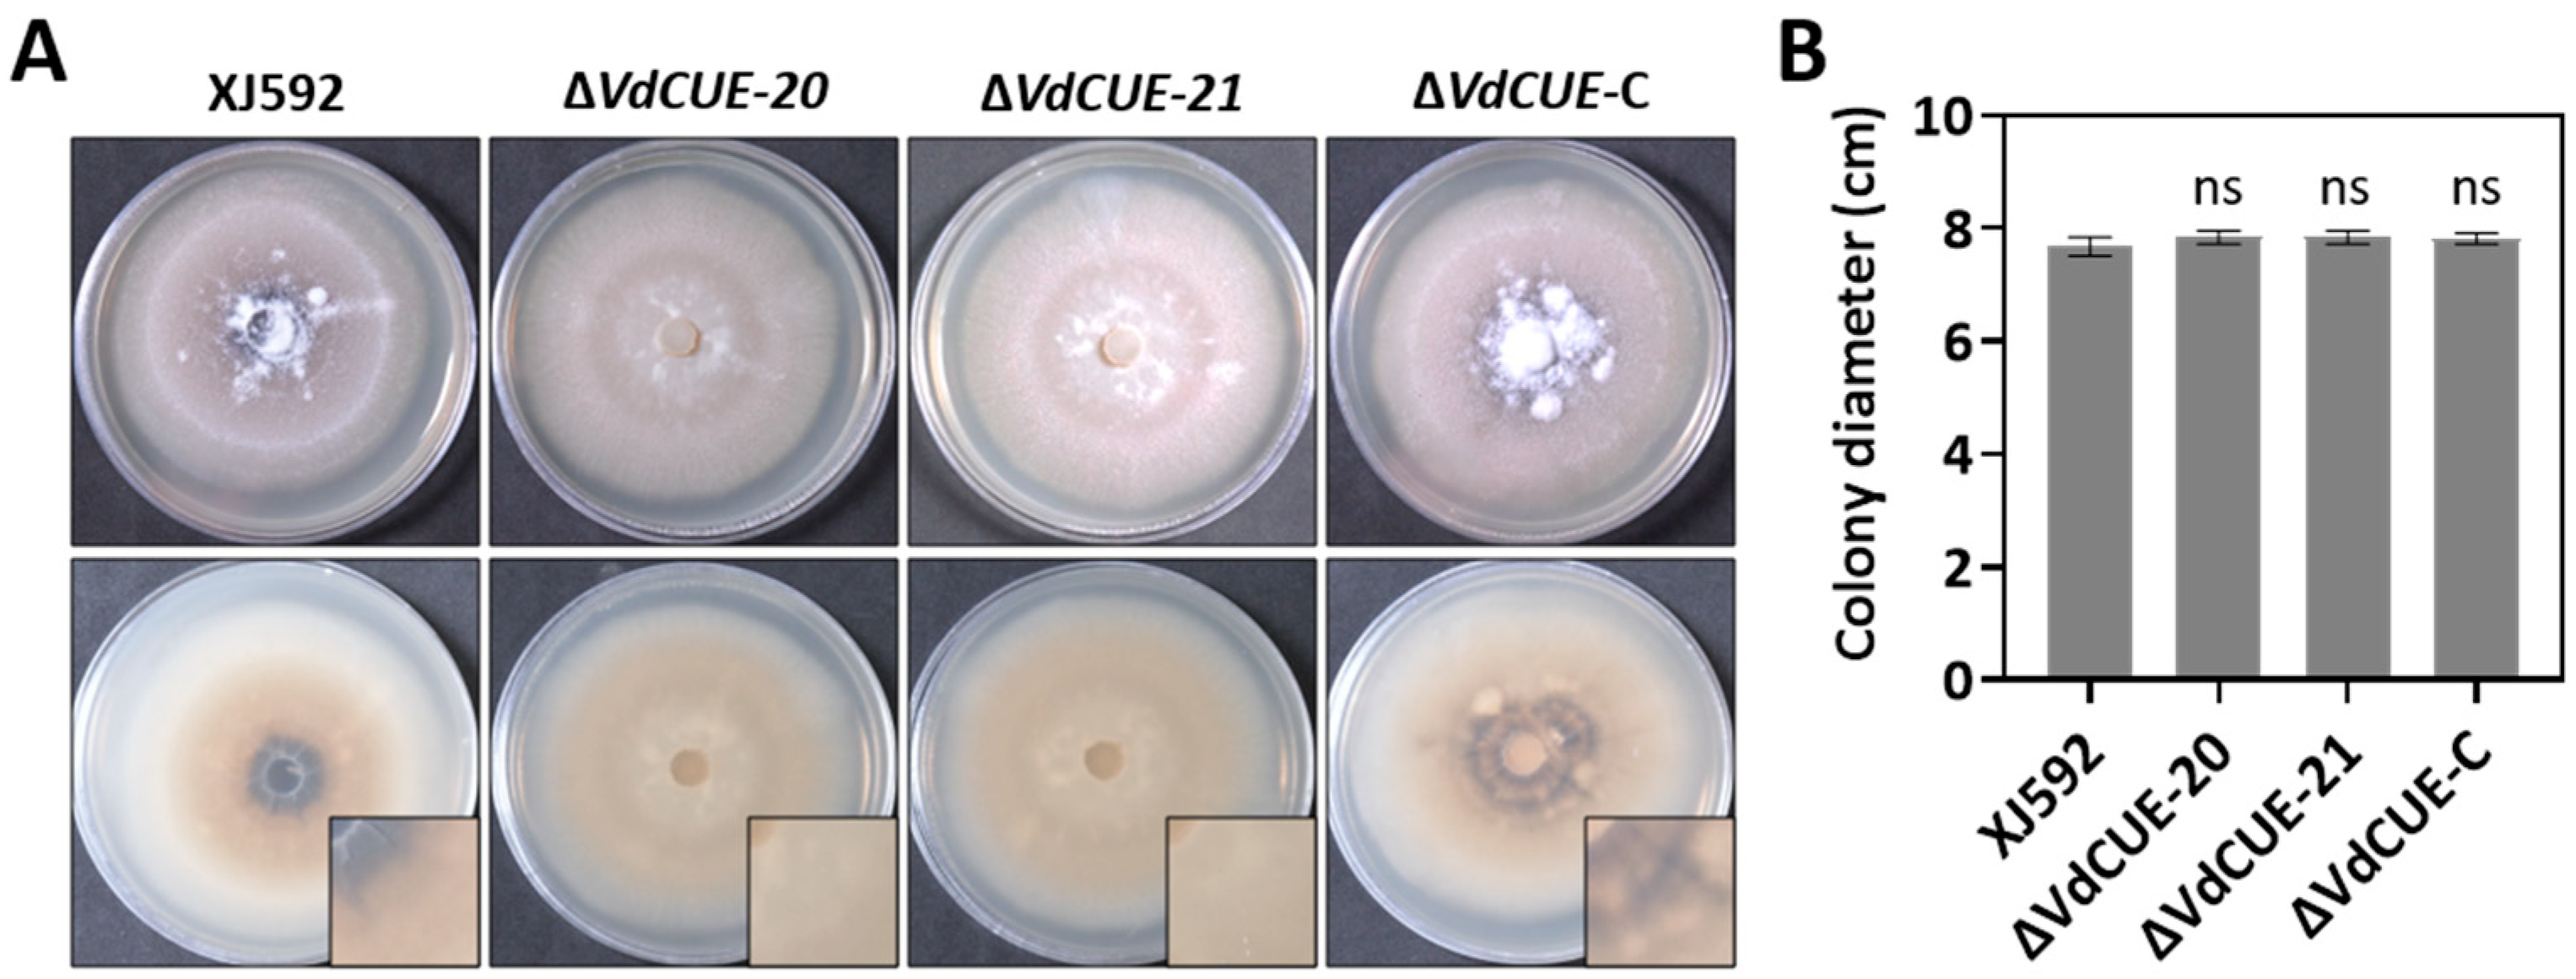

Secreted Protein VdCUE Modulates Virulence of Verticillium dahliae Without Interfering with BAX-Induced Cell Death
Abstract
1. Introduction
2. Materials and Methods
2.1. Fungal Strains, Plant Materials, and Culture Conditions
2.2. Deletion and Complementation of VdCUE in XJ592
2.3. Growth Rate and Microsclerotia Formation Assays
2.4. Virulence Assessment Assays
2.5. Sequence Analysis
2.6. Yeast Secretion Assays
2.7. Agroinfiltration Assays
2.8. Yeast Two-Hybrid (Y2H) Screening for Interaction Targets
2.9. Y2H-AOS
2.10. Statistical Analysis
3. Results
3.1. VdCUE Regulates Microsclerotia Formation but Not Growth in V. dahliae
3.2. VdCUE Positively Regulates Virulence and Cotton Defoliation in Strain XJ592
3.3. VdCUE Contains a Functional SP and a CUE Domain
3.4. VdCUE Is Not Involved in the Regulation of Plant Programmed Cell Death
3.5. Three Potential VdCUE-Interacting Proteins Were Identified by Y2H Screening
4. Discussion
Supplementary Materials
Author Contributions
Funding
Institutional Review Board Statement
Informed Consent Statement
Data Availability Statement
Acknowledgments
Conflicts of Interest
References
- Bhat, R.G.; Subbarao, K.V. Host range specificity in Verticillium dahliae. Phytopathology 1999, 89, 1218–1225. [Google Scholar] [CrossRef] [PubMed]
- Guo, R.; Li, B.; Zhao, Y.; Tang, C.; Klosterman, S.J.; Wang, Y. Rhizobacterial Bacillus enrichment in soil enhances smoke tree resistance to Verticillium wilt. Plant Cell Environ. 2024, 47, 4086–4100. [Google Scholar] [CrossRef]
- Montes-Osuna, N.; Mercado-Blanco, J. Verticillium wilt of olive and its control: What did we learn during the last decade? Plants 2020, 9, 735. [Google Scholar] [CrossRef]
- Wilhelm, S. Longevity of the Verticillium wilt fungus in the laboratory and field. Phytopathology 1955, 45, 180–181. [Google Scholar]
- Zhang, D.D.; Dai, X.F.; Klosterman, S.J.; Subbarao, K.V.; Chen, J.Y. The secretome of Verticillium dahliae in collusion with plant defence responses modulates Verticillium wilt symptoms. Biol. Rev. Camb. Philos. Soc. 2022, 97, 1810–1822. [Google Scholar] [CrossRef]
- Li, C.; Qin, J.; Huang, Y.; Shang, W.; Chen, J.; Klosterman, S.J.; Subbarao, K.V.; Hu, X. Verticillium dahliae effector VdCE11 contributes to virulence by promoting accumulation and activity of the aspartic protease GhAP1 from cotton. Microbiol. Spectr. 2023, 11, e0354722. [Google Scholar] [CrossRef]
- Wang, Y.; Liao, X.; Shang, W.; Qin, J.; Xu, X.; Hu, X. The secreted feruloyl esterase of Verticillium dahliae modulates host immunity via degradation of GhDFR. Mol. Plant Pathol. 2024, 25, e13431. [Google Scholar] [CrossRef] [PubMed]
- Qin, J.; Wang, K.; Sun, L.; Xing, H.; Wang, S.; Li, L.; Chen, S.; Guo, H.S.; Zhang, J. The plant-specific transcription factors CBP60g and SARD1 are targeted by a Verticillium secretory protein VdSCP41 to modulate immunity. Elife 2018, 7, e34902. [Google Scholar] [CrossRef]
- Zhang, L.; Ni, H.; Du, X.; Wang, S.; Ma, X.W.; Nürnberger, T.; Guo, H.S.; Hua, C. The Verticillium-specific protein VdSCP7 localizes to the plant nucleus and modulates immunity to fungal infections. New Phytol. 2017, 215, 368–381. [Google Scholar] [CrossRef] [PubMed]
- Liu, S.; Liu, R.; Lv, J.; Feng, Z.; Wei, F.; Zhao, L.; Zhang, Y.; Zhu, H.; Feng, H. The glycoside hydrolase 28 member VdEPG1 is a virulence factor of Verticillium dahliae and interacts with the jasmonic acid pathway-related gene GhOPR9. Mol. Plant Pathol. 2023, 24, 1238–1255. [Google Scholar] [CrossRef]
- Wang, D.; Tian, L.; Zhang, D.D.; Song, J.; Song, S.S.; Yin, C.M.; Zhou, L.; Liu, Y.; Wang, B.L.; Kong, Z.Q.; et al. Functional analyses of small secreted cysteine-rich proteins identified candidate effectors in Verticillium dahliae. Mol. Plant Pathol. 2020, 21, 667–685. [Google Scholar] [CrossRef]
- Yin, Z.; Wang, N.; Pi, L.; Li, L.; Duan, W.; Wang, X.; Dou, D. Nicotiana benthamiana LRR-RLP NbEIX2 mediates the perception of an EIX-like protein from Verticillium dahliae. J. Integr. Plant Biol. 2021, 63, 949–960. [Google Scholar] [CrossRef]
- Hershko, A.; Ciechanover, A. The ubiquitin system. Annu. Rev. Biochem. 1998, 67, 425–479. [Google Scholar] [CrossRef] [PubMed]
- Meusser, B.; Hirsch, C.; Jarosch, E.; Sommer, T. ERAD: The long road to destruction. Nat. Cell Biol. 2005, 7, 766–772. [Google Scholar] [CrossRef] [PubMed]
- Kang, R.S.; Daniels, C.M.; Francis, S.A.; Shih, S.C.; Salerno, W.J.; Hicke, L.; Radhakrishnan, I. Solution structure of a CUE-ubiquitin complex reveals a conserved mode of ubiquitin binding. Cell 2003, 113, 621–630. [Google Scholar] [CrossRef] [PubMed]
- von Delbrück, M.; Kniss, A.; Rogov, V.V.; Pluska, L.; Bagola, K.; Löhr, F.; Güntert, P.; Sommer, T.; Dötsch, V. The CUE domain of Cue1 aligns growing ubiquitin chains with Ubc7 for rapid elongation. Mol. Cell. 2016, 62, 918–928. [Google Scholar] [CrossRef]
- Tomomatsu, S.; Watanabe, A.; Tesina, P.; Hashimoto, S.; Ikeuchi, K.; Li, S.; Matsuo, Y.; Beckmann, R.; Inada, T. Two modes of Cue2-mediated mRNA cleavage with distinct substrate recognition initiate no-go decay. Nucleic Acids Res. 2023, 51, 253–270. [Google Scholar] [CrossRef]
- Hama, H.; Tall, G.G.; Horazdovsky, B.F. Vps9p is a guanine nucleotide exchange factor involved in vesicle-mediated vacuolar protein transport. J. Biol. Chem. 1999, 274, 15284–15291. [Google Scholar] [CrossRef]
- Nakase, M.; Tsukamoto, Y.; Hosomi, A.; Matsuda, T.; Miyamoto, M.; Takegawa, K. CUE domain-containing protein Vps901 is required for vacuolar protein transport in Schizosaccharomyces pombe. Biosci. Biotechnol. Biochem. 2012, 76, 652–659. [Google Scholar] [CrossRef][Green Version]
- Kawasaki, T.; Nam, J.; Boyes, D.C.; Holt, B.F., 3rd; Hubert, D.A.; Wiig, A.; Dangl, J.L. A duplicated pair of Arabidopsis RING-finger E3 ligases contribute to the RPM1- and RPS2-mediated hypersensitive response. Plant J. 2005, 44, 258–270. [Google Scholar] [CrossRef]
- Tsumoto, Y.; Yoshizumi, T.; Kuroda, H.; Kawashima, M.; Ichikawa, T.; Nakazawa, M.; Yamamoto, N.; Matsui, M. Light-dependent polyploidy control by a CUE protein variant in Arabidopsis. Plant Mol. Biol. 2006, 61, 817–828. [Google Scholar] [CrossRef]
- Ma, J.; Wang, Y.; Ma, X.; Meng, L.; Jing, R.; Wang, F.; Wang, S.; Cheng, Z.; Zhang, X.; Jiang, L.; et al. Disruption of gene SPL35, encoding a novel CUE domain-containing protein, leads to cell death and enhanced disease response in rice. Plant Biotechnol. J. 2019, 17, 1679–1693. [Google Scholar] [CrossRef]
- Lim, Y.J.; Lee, Y.H. F-box only and CUE proteins are crucial ubiquitination-associated components for conidiation and pathogenicity in the rice blast fungus, Magnaporthe oryzae. Fungal Genet. Biol. 2020, 144, 103473. [Google Scholar] [CrossRef]
- Li, H.; Dai, J.; Qin, J.; Shang, W.; Chen, J.; Zhang, L.; Dai, X.; Klosterman, S.J.; Xu, X.; Subbarao, K.V.; et al. Genome sequences of Verticillium dahliae defoliating strain XJ592 and nondefoliating strain XJ511. Mol. Plant Microbe Interact. 2020, 33, 565–568. [Google Scholar] [CrossRef]
- Wang, S.; Xing, H.; Hua, C.; Guo, H.S.; Zhang, J. An improved single-step cloning strategy simplifies the Agrobacterium tumefaciens-mediated transformation (ATMT)-based gene-disruption method for Verticillium dahliae. Phytopathology 2016, 106, 645–652. [Google Scholar] [CrossRef]
- Jacobs, K.A.; Collins-Racie, L.A.; Colbert, M.; Duckett, M.; Golden-Fleet, M.; Kelleher, K.; Kriz, R.; LaVallie, E.R.; Merberg, D.; Spaulding, V.; et al. A genetic selection for isolating cDNAs encoding secreted proteins. Gene 1997, 198, 289–296. [Google Scholar] [CrossRef]
- Oh, S.K.; Young, C.; Lee, M.; Oliva, R.; Bozkurt, T.O.; Cano, L.M.; Win, J.; Bos, J.I.; Liu, H.Y.; van Damme, M.; et al. In planta expression screens of Phytophthora infestans RXLR effectors reveal diverse phenotypes, including activation of the Solanum bulbocastanum disease resistance protein Rpi-blb2. Plant Cell 2009, 21, 2928–2947. [Google Scholar] [CrossRef]
- Yang, Z.; Zeng, X.; Zhao, Y.; Chen, R. AlphaFold2 and its applications in the fields of biology and medicine. Signal Transduct Target Ther. 2023, 8, 115. [Google Scholar] [CrossRef]
- Yan, Y.; Zhang, D.; Zhou, P.; Li, B.; Huang, S.Y. HDOCK: A web server for protein-protein and protein-DNA/RNA docking based on a hybrid strategy. Nucleic Acids Res. 2017, 45, W365–W373. [Google Scholar] [CrossRef]
- Li, B.; Liu, X.; Zang, J.; Cao, H.; Si, H.; Zhang, K.; Xing, J.; Dong, J. Kynurenine monooxygenase BcKMOL: A key regulator of growth, pathogenicity, and disease control in Botrytis cinerea. Front. Microbiol. 2025, 16, 1595008. [Google Scholar] [CrossRef]
- Bell, A.A.; Wheeler, M.H. Biosynthesis and functions of fungal melanins. Annu. Rev. Phytopathol. 1986, 24, 411–451. [Google Scholar] [CrossRef]
- Liu, T.; Qin, J.; Cao, Y.; Subbarao, K.V.; Chen, J.; Mandal, M.K.; Xu, X.; Shang, W.; Hu, X. Transcription factor VdCf2 regulates growth, pathogenicity, and the expression of a putative secondary metabolism gene cluster in Verticillium dahliae. Appl. Environ. Microbiol. 2022, 88, e0138522. [Google Scholar] [CrossRef] [PubMed]
- Li, H.; Sheng, R.C.; Zhang, C.N.; Wang, L.C.; Li, M.; Wang, Y.H.; Qiao, Y.H.; Klosterman, S.J.; Chen, J.Y.; Kong, Z.Q.; et al. Two zinc finger proteins, VdZFP1 and VdZFP2, interact with VdCmr1 to promote melanized microsclerotia development and stress tolerance in Verticillium dahliae. BMC Biol. 2023, 21, 237. [Google Scholar] [CrossRef]
- Li, H.; Liu, Y.; Wang, D.; Wang, Y.H.; Sheng, R.C.; Kong, Z.Q.; Klosterman, S.J.; Chen, J.Y.; Subbarao, K.V.; Chen, F.M.; et al. The 24-kDa subunit of mitochondrial complex I regulates growth, microsclerotia development, stress tolerance, and virulence in Verticillium dahliae. BMC Biol. 2024, 22, 289. [Google Scholar] [CrossRef]
- Kumari, S.; Joshi, R.; Singh, K.; Roy, S.; Tripathi, A.K.; Singh, P.; Singla-Pareek, S.L.; Pareek, A. Expression of a cyclophilin OsCyp2-P isolated from a salt-tolerant landrace of rice in tobacco alleviates stress via ion homeostasis and limiting ROS accumulation. Funct. Integr. Genom. 2015, 15, 395–412. [Google Scholar] [CrossRef]
- Pogorelko, G.V.; Mokryakova, M.; Fursova, O.V.; Abdeeva, I.; Piruzian, E.S.; Bruskin, S.A. Characterization of three Arabidopsis thaliana immunophilin genes involved in the plant defense response against Pseudomonas syringae. Gene 2014, 538, 12–22. [Google Scholar] [CrossRef]
- Kovalev, N.; Nagy, P.D. Cyclophilin A binds to the viral RNA and replication proteins, resulting in inhibition of tombusviral replicase assembly. J. Virol. 2013, 87, 13330–13342. [Google Scholar] [CrossRef] [PubMed]
- Qin, T.; Liu, S.; Zhang, Z.; Sun, L.; He, X.; Lindsey, K.; Zhu, L.; Zhang, X. GhCyP3 improves the resistance of cotton to Verticillium dahliae by inhibiting the E3 ubiquitin ligase activity of GhPUB17. Plant Mol. Biol. 2019, 99, 379–393. [Google Scholar] [CrossRef]
- Zorzatto, C.; Machado, J.P.; Lopes, K.V.; Nascimento, K.J.; Pereira, W.A.; Brustolini, O.J.; Reis, P.A.; Calil, I.P.; Deguchi, M.; Sachetto-Martins, G.; et al. NIK1-mediated translation suppression functions as a plant antiviral immunity mechanism. Nature 2015, 520, 679–682. [Google Scholar] [CrossRef]
- Liu, J.; Hu, Y.; Lu, X.; Xu, J.; Wang, H.; Tang, W.; Li, C. The role of ribosomal protein StRPS5 in mediating resistance of Solanum tuberosum plants to Phytophthora infestans. Plant Sci. 2025, 357, 112539. [Google Scholar] [CrossRef]
- Zhu, D.; Zhang, X.; Zhou, J.; Wu, Y.; Zhang, X.; Feng, Z.; Wei, F.; Zhao, L.; Zhang, Y.; Shi, Y.; et al. Genome-wide analysis of ribosomal protein GhRPS6 and its role in cotton Verticillium wilt resistance. Int. J. Mol. Sci. 2021, 22, 1795. [Google Scholar] [CrossRef] [PubMed]
- Gong, Q.; Yang, Z.; Wang, X.; Butt, H.I.; Chen, E.; He, S.; Zhang, C.; Zhang, X.; Li, F. Salicylic acid-related cotton (Gossypium arboreum) ribosomal protein GaRPL18 contributes to resistance to Verticillium dahliae. BMC Plant Biol. 2017, 17, 59. [Google Scholar] [CrossRef] [PubMed]
- Björk, G.R.; Huang, B.; Persson, O.P.; Byström, A.S. A conserved modified wobble nucleoside (mcm5s2U) in lysyl-tRNA is required for viability in yeast. RNA 2007, 13, 1245–1255. [Google Scholar] [CrossRef] [PubMed]
- Dewez, M.; Bauer, F.; Dieu, M.; Raes, M.; Vandenhaute, J.; Hermand, D. The conserved Wobble uridine tRNA thiolase Ctu1-Ctu2 is required to maintain genome integrity. Proc. Natl. Acad. Sci. USA 2008, 105, 5459–5464. [Google Scholar] [CrossRef]
- Philipp, M.; John, F.; Ringli, C. The cytosolic thiouridylase CTU2 of Arabidopsis thaliana is essential for posttranscriptional thiolation of tRNAs and influences root development. BMC Plant Biol. 2014, 14, 109. [Google Scholar] [CrossRef]
- Zheng, X.; Chen, H.; Deng, Z.; Wu, Y.; Zhong, L.; Wu, C.; Yu, X.; Chen, Q.; Yan, S. The tRNA thiolation-mediated translational control is essential for plant immunity. Elife 2024, 13, e93517. [Google Scholar] [CrossRef]
- Bagola, K.; von Delbrück, M.; Dittmar, G.; Scheffner, M.; Ziv, I.; Glickman, M.H.; Ciechanover, A.; Sommer, T. Ubiquitin binding by a CUE domain regulates ubiquitin chain formation by ERAD E3 ligases. Mol. Cell 2013, 50, 528–539. [Google Scholar] [CrossRef]
- Jiang, C.; Hei, R.; Yang, Y.; Zhang, S.; Wang, Q.; Wang, W.; Zhang, Q.; Yan, M.; Zhu, G.; Huang, P.; et al. An orphan protein of Fusarium graminearum modulates host immunity by mediating proteasomal degradation of TaSnRK1α. Nat. Commun. 2020, 11, 4382. [Google Scholar] [CrossRef]
- Qin, J.; Zhou, X.; Sun, L.; Wang, K.; Yang, F.; Liao, H.; Rong, W.; Yin, J.; Chen, H.; Chen, X.; et al. The Xanthomonas effector XopK harbours E3 ubiquitin-ligase activity that is required for virulence. New Phytol. 2018, 220, 219–231. [Google Scholar] [CrossRef] [PubMed]

| Bait Protein | Target Protein Gene ID | Functional Annotation |
|---|---|---|
| VdCUE | LOC107959305 | tRNA-specific 2-thiouridylase |
| LOC107953988 | Peptidyl-prolyl cis-trans isomerase | |
| LOC107962302 | 40S ribosomal protein |
Disclaimer/Publisher’s Note: The statements, opinions and data contained in all publications are solely those of the individual author(s) and contributor(s) and not of MDPI and/or the editor(s). MDPI and/or the editor(s) disclaim responsibility for any injury to people or property resulting from any ideas, methods, instructions or products referred to in the content. |
© 2025 by the authors. Licensee MDPI, Basel, Switzerland. This article is an open access article distributed under the terms and conditions of the Creative Commons Attribution (CC BY) license (https://creativecommons.org/licenses/by/4.0/).
Share and Cite
Yu, H.; Li, H.; Zhang, X.; Wei, M.; Hu, X.; Qin, J. Secreted Protein VdCUE Modulates Virulence of Verticillium dahliae Without Interfering with BAX-Induced Cell Death. J. Fungi 2025, 11, 660. https://doi.org/10.3390/jof11090660
Yu H, Li H, Zhang X, Wei M, Hu X, Qin J. Secreted Protein VdCUE Modulates Virulence of Verticillium dahliae Without Interfering with BAX-Induced Cell Death. Journal of Fungi. 2025; 11(9):660. https://doi.org/10.3390/jof11090660
Chicago/Turabian StyleYu, Haonan, Haiyuan Li, Xiaochen Zhang, Mengmeng Wei, Xiaoping Hu, and Jun Qin. 2025. "Secreted Protein VdCUE Modulates Virulence of Verticillium dahliae Without Interfering with BAX-Induced Cell Death" Journal of Fungi 11, no. 9: 660. https://doi.org/10.3390/jof11090660
APA StyleYu, H., Li, H., Zhang, X., Wei, M., Hu, X., & Qin, J. (2025). Secreted Protein VdCUE Modulates Virulence of Verticillium dahliae Without Interfering with BAX-Induced Cell Death. Journal of Fungi, 11(9), 660. https://doi.org/10.3390/jof11090660

